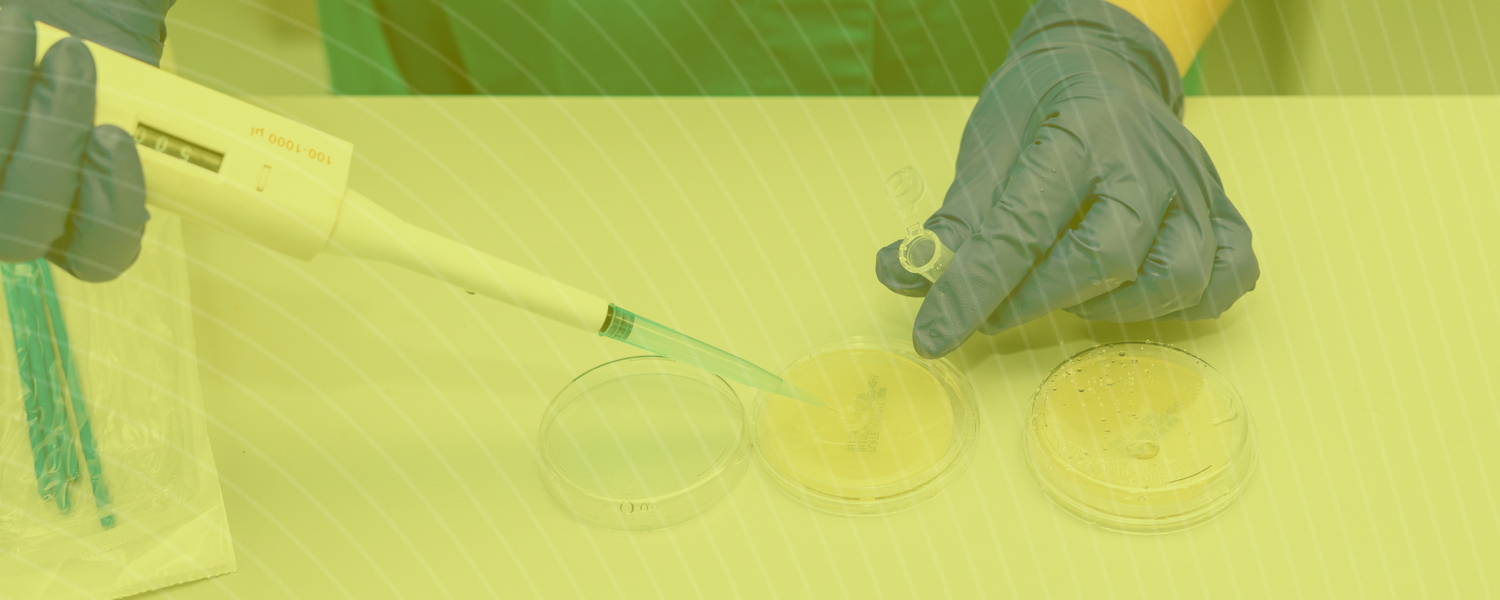

CALIDAD Y SEGURIDAD EN CADA FÓRMULA
Nuestro equipo de expertos desarrollan productos eficaces desde las fórmulas en nuestros laboratorios hasta el empaquetado, garantizando una cadena segura en todo momento.
Cumplimos con la normativa ISO 9001: 2015, ISO 22.000 además de con los requisitos de la UE y la normativa alimentaria APPCC.
En SOTYA dedicamos todo nuestro esfuerzo a hacer las cosas bien.
-
En nuestros laboratorios de Sotya empleamos exclusivamente materias primas de la más alta calidad, con análisis completos verificados en nuestro laboratorio.
-
Nuestros envases son de PET de calidad alimentaria, con tapón de precinto para garantizar seguridad e higiene, demostrando nuestro compromiso con la seguridad alimentaria.
-
Nos esforzamos por la sostenibilidad, reciclando todos los subproductos, envases y embalajes resultantes de nuestra fabricación, como parte de nuestro compromiso con el medio ambiente.